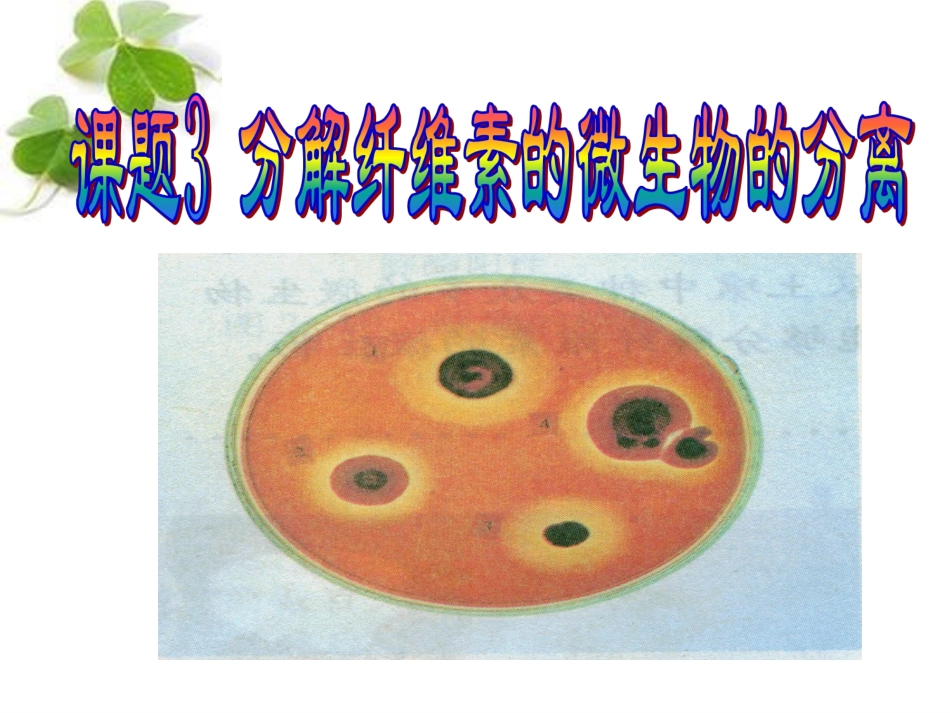
课题3-分解纤维素的微生物的分离-(2)_第1页

纤维素:棉花是自然界中纤维素含量最高的天然产物;纤维素是地球上含量最丰富的多糖类物质,植物每年产生的纤维素超过70亿吨;分布植物的根、茎、叶中;基础知识1
纤维纤维素素纤维素是一种由纤维素是一种由葡萄糖葡萄糖首尾相连而成首尾相连而成的的高分子高分子化合物,是含量最丰富的化合物,是含量最丰富的多糖多糖类物质
土壤中某些微生物能够产生土壤中某些微生物能够产生纤维素酶,,把纤维素分解为葡萄糖,后再利用把纤维素分解为葡萄糖,后再利用
纤维素酶纤维素酶纤维素酶是一种纤维素酶是一种复合酶复合酶,一般认为它,一般认为它至少包至少包括三种组分括三种组分,即,即CC11酶酶((外切酶外切酶))、、CCXX酶酶((内切内切酶酶))和葡萄糖苷酶和葡萄糖苷酶,前两种酶使纤维素分解成,前两种酶使纤维素分解成纤维二糖,第三种酶将纤维二糖分解成葡萄糖
纤维二糖,第三种酶将纤维二糖分解成葡萄糖
纤维二糖C1酶、Cx酶葡萄糖苷酶葡萄糖纤维素基础知识滤纸崩溃法体会纤维素酶作用的实验:(2)纤维素分解菌的筛选1、筛选纤维素分解菌的方法______________
该方法可以通过________反应直接筛选
刚果红染色法颜色2、其原理是:刚果红可以与纤维素形成____________,当纤维素被_________分解后,红色复合物无法形成,出现以_____________为中心的________,可以通过___________________________来筛选纤维素分解菌
红色复合物纤维素酶纤维素分解菌透明圈是否产生透明圈可根据是否产生透明圈来筛选纤维素分解菌练一练:1
下列关于纤维素酶的说法,错误的是A
纤维素酶是一种复合酶,至少包括三种B
纤维素酶可把纤维素分解成葡萄糖C
纤维素酶可用于去掉植物的细胞壁D
葡萄糖苷酶可把纤维素分解成葡萄糖2
利用刚果红法可以筛选出纤维素分解菌,下列说